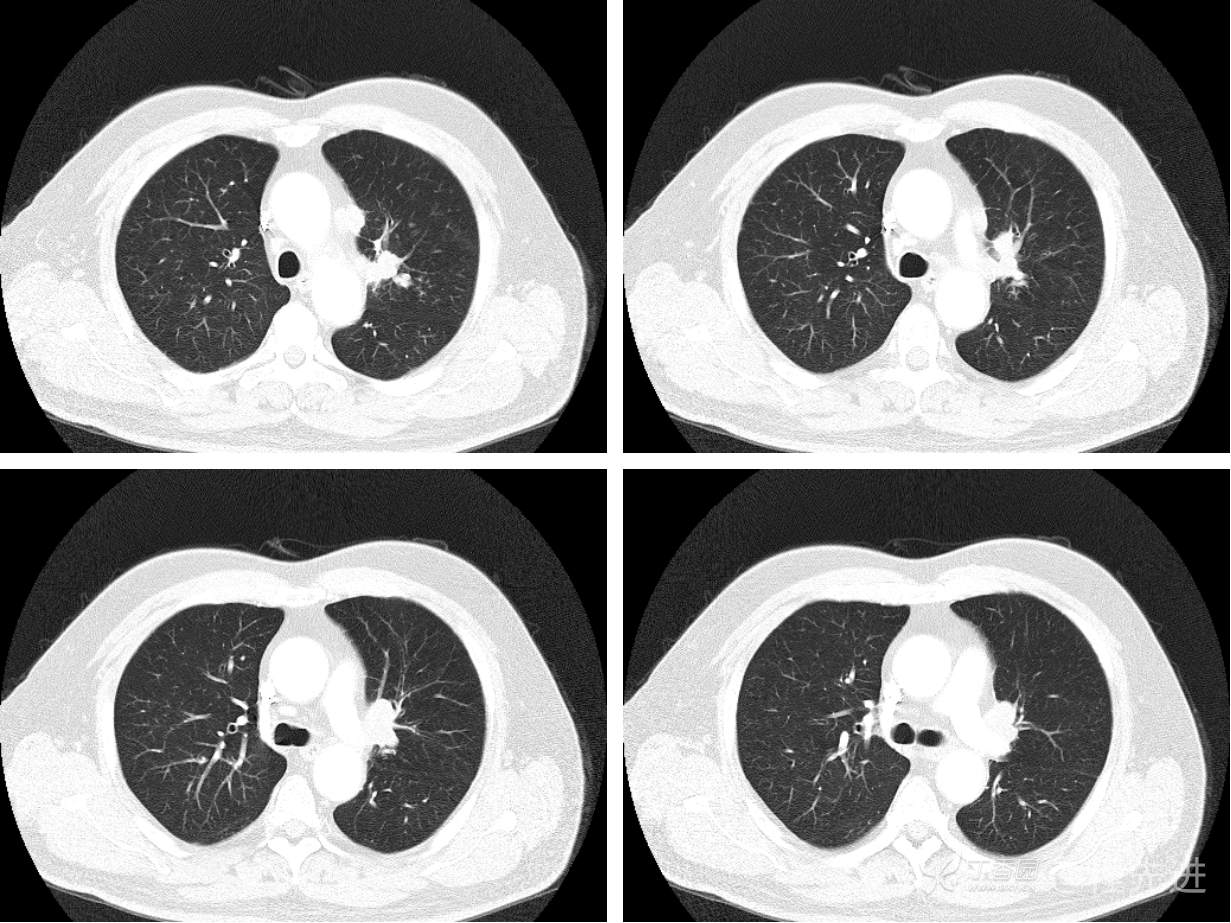
img

3月特别精彩病例|咳嗽胸闷半月,左肺上叶支气管内肿物等你来详解【病理已公布】
呱呱叫了 等 3 位达人已点赞患者性别:男
患者年龄:67岁
主诉:咳嗽胸闷半月入院。
流行病学情况:患者老年男性,因咳嗽胸闷症状入院,既往有长期吸烟史及高血压病史。
现病史概要:患者入院前约半月无明显诱因下出现咳嗽、胸闷症状,无明显发热症状,咳少量白痰,无明显咯血、喘息、头晕等不适,就诊我院查胸部CT示上纵膈肿物,左肺上叶支气管内肿物,现为行进一步治疗收入胸外科,患者近来饮食睡眠尚可,二便如常。
体格检查:体温 36.7℃ 脉搏85次/分呼吸20次/分血压161/95mmHg神清语畅,头颅五官无畸形,颈部左侧胸锁乳突肌旁可触及一直径约 lcm肿物,质软,无压痛,腹部检查未见明显异常,四肢活动可,病理征未引出。颈部气管居中,全身浅表淋巴结未触乃肿大,胸廊对称无酶形,呼吸运动正常胸部无压痛,胸骨无叩痛,胸廊挤压征阴性,听诊双肺呼吸音存,未闻及干、湿性啰音,未触及心前区震颤,无心包摩擦感,心浊音界正常,叩诊正常,心音有力,心律齐,心率85次/分,各辨膜听诊区未及杂音。